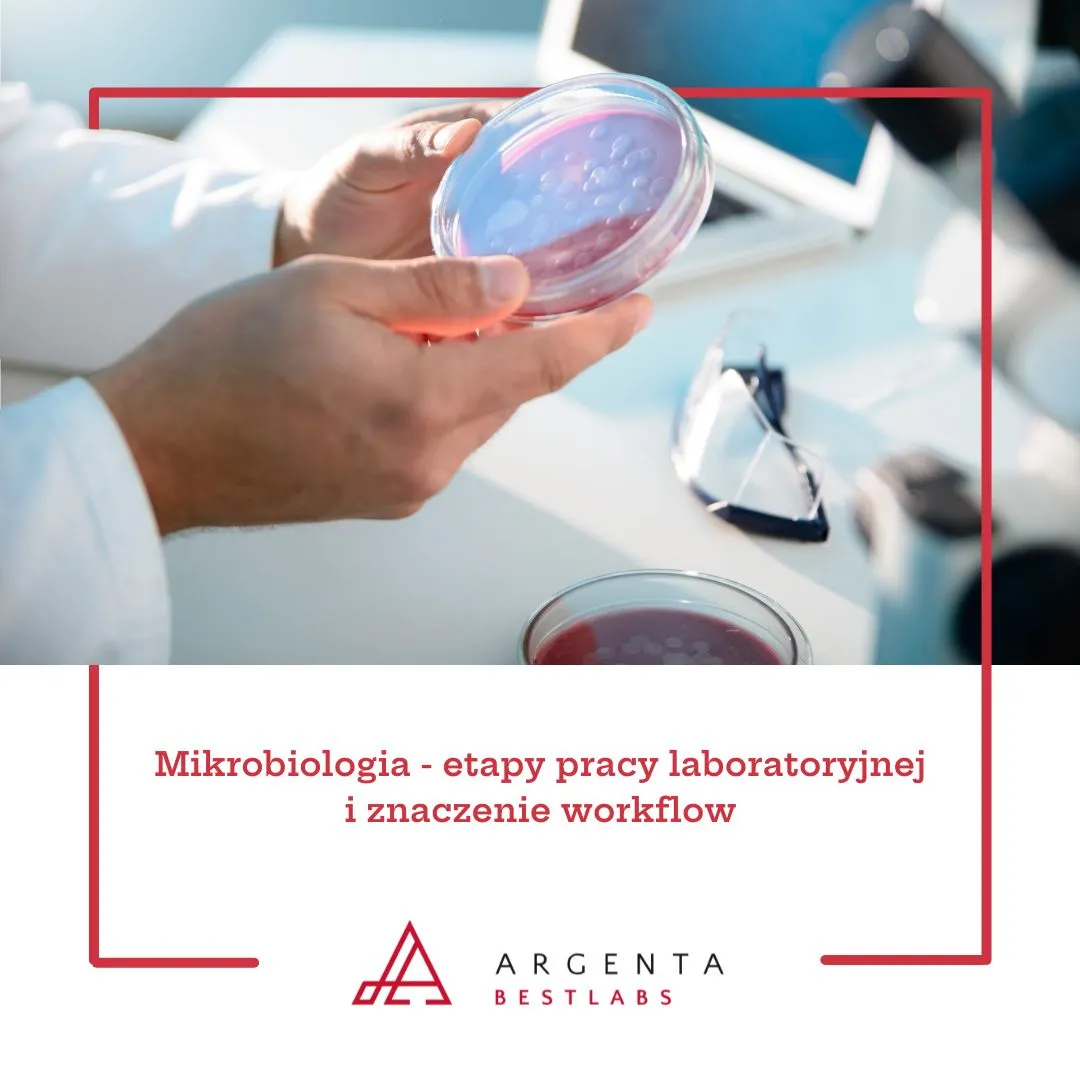
Mikrobiologia - etapy pracy laboratoryjnej i znaczenie workflow

Liofilchem ComASP® - panele do oznaczania MIC metodą mikrorozcieńczeń
ComASP® to gotowe panele Liofilchem do oznaczania MIC metodą mikrorozcieńczeń w bulionie. Rozwiązanie wspiera diagnostykę lekowrażliwości bakterii i drożdżaków oraz interpretację wyników zgodnie...
czytaj całość